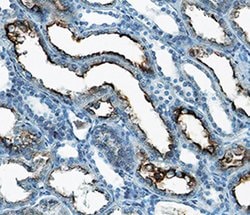
Human PTH1R/PTHR1 Antibody, R D Systems:Antibodies:Primary Antibodies

missing translation for 'onlineSavingsMsg'
Learn More
Learn More
Human PTH1R/PTHR1 Antibody, R&D Systems™


Mouse Monoclonal Antibody
191.00 € - 399.00 €
Specifications
| Antigen | PTH1R/PTHR1 |
|---|---|
| Clone | 542407 |
| Dilution | Immunohistochemistry 8-25 ug/mL |
| Applications | Immunohistochemistry |
| Classification | Monoclonal |
| Product Code | Brand | Quantity | Price | Quantity & Availability | |||||
|---|---|---|---|---|---|---|---|---|---|
| Product Code | Brand | Quantity | Price | Quantity & Availability | |||||
18725339
 |
R&D Systems
MAB57091-SP |
25 μg |
191.00 €
25µg |
Please sign in to purchase this item. Need a web account? Register with us today! | |||||
18767608
 |
R&D Systems
MAB57091-100 |
100 μg |
399.00 €
100µg |
Please sign in to purchase this item. Need a web account? Register with us today! | |||||
Description
PTH1R/PTHR1 Monoclonal specifically detects PTH1R/PTHR1 in Human samples. It is validated for Immunohistochemistry.Specifications
| PTH1R/PTHR1 | |
| Immunohistochemistry 8-25 ug/mL | |
| Monoclonal | |
| Purified | |
| RUO | |
| Lyophilized from a 0.2 μm filtered solution in PBS with Trehalose. *Small pack size (SP) is supplied as a 0.2 μm filtered solution in PBS. | |
| MGC138426, parathyroid hormone 1 receptorMGC138452, parathyroid hormone/parathyroid hormone-related peptide receptor, parathyroid hormone/parathyroid hormone-related protein receptor, PFE, PTH/PTHr receptor, PTH/PTHrP type I receptor, PTH1 receptor, PTHR, PTHR1, PTHRPTHR1parathyroid hormone receptor 1, seven transmembrane helix receptor | |
| Chinese hamster ovary cell line CHO-derived recombinant human PTHR1 Tyr23-Met189 Accession # Q03431 | |
| Primary | |
| Reconstitute at 0.5 mg/mL in sterile PBS. | |
| Detects human PTHR1 in direct ELISAs. |
| 542407 | |
| Immunohistochemistry | |
| Unconjugated | |
| Mouse | |
| Human | |
| Q03431 | |
| 5745 | |
| IgG2a | |
| Protein A or G purified from hybridoma culture supernatant | |
| Use a manual defrost freezer and avoid repeated freeze-thaw cycles. 12 months from date of receipt, -20 to -70 degreesC as supplied. 1 month, 2 to 8 degreesC under sterile conditions after reconstitution. 6 months, -20 to -70 degreesC under sterile conditions after reconstitution. |
RUO
Spot an opportunity for improvement?Share a Content Correction
Product Content Correction
Your input is important to us. Please complete this form to provide feedback related to the content on this product.
Product Title